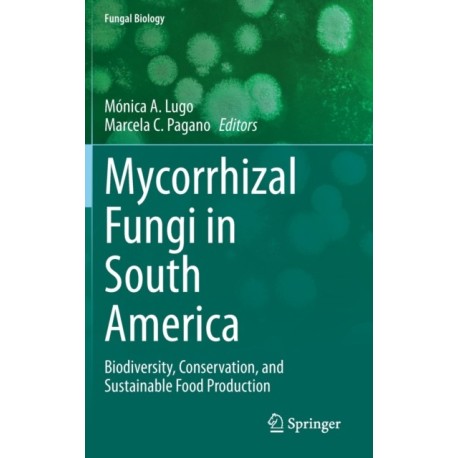
Mycorrhizal Fungi in South America: Biodiversity, Conservation, and Sustainable Food Production

Kurv
Vare
varer
(tom)
Ingen varer
Fastlægges senere
Forsendelse
0,- kr
I alt
Mycorrhizal Fungi in South America: Biodiversity, Conservation, and Sustainable Food Production
(Bog, Hardback, Engelsk)
- Type: Bog
- Format: Hardback
-
Sprog:
Engelsk

- ISBN-13: 9783031129933
- Se flere detaljer ▼
Bemærk: Kan ikke leveres før jul.
Beskrivelse
It includes new reports of mycorrhizal fungi diversity along different mycorrhizal types and their effect on plant communities, plant invasions, the use of mycorrhizal fungi for ecological and sustainable studies, management programs of natural and agroecosystems, and forestry and food-secure production.
Læsernes anmeldelser (0)
Alle detaljer
| Forlag | Springer International Publishing AG |
| Type | Bog |
| Format | Hardback |
| Sprog | Engelsk |
| Udgave | 2022 ed. |
| Udgivelsesdato | 28-10-2022 |
| Første udgivelsesår | 2022 |
| Serie | Fungal Biology |
| Illustrationer | 58 Illustrations, color; 7 Illustrations, black and white; VIII, 465 p. 65 illus., 58 illus. in color. |
| Fagredaktør | Monica A. Lugo, Marcela C. Pagano |
| Originalsprog | Switzerland |
| Sideantal | 465 |
| Indbinding | Hardback |
| Forlag | Springer International Publishing AG |
| Sideoplysninger | 465 pages, 58 Illustrations, color; 7 Illustrations, black and white; VIII, 465 p. 65 illus., 58 ill |
| Mål | 235 x 155 |
| ISBN-13 / EAN-13 | 9783031129933 |

